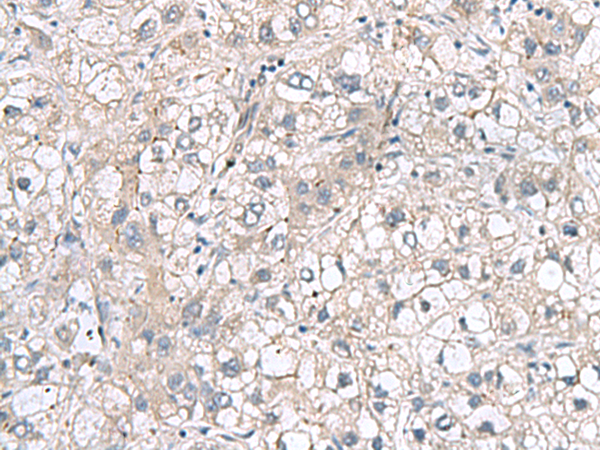

-
分类: 科研抗体货号: P10257别名: LC1; CILD16; C14orf168应用: IHC反应种属: Human, Mouse, Rat
-
分类: 科研抗体货号: P10241别名: SIP3应用: IHC反应种属: Human, Mouse
-
分类: 科研抗体货号: P10277别名:应用: WB,IHC反应种属: Human, Mouse
-
分类: 科研抗体货号: P10256别名: S14; EMTB应用: WB,IHC反应种属: Human, Mouse, Rat
-
分类: 科研抗体货号: P10240别名: H2AFJ应用: WB,IHC反应种属: Human, Mouse, Rat
-
分类: 科研抗体货号: P10275别名: MED30S; THRAP6; TRAP25应用: WB,IHC反应种属: Human, Mouse
-
分类: 科研抗体货号: P10255别名: MLC1F; MLC3F应用: IHC反应种属: Human, Mouse, Rat
-
分类: 科研抗体货号: P10238别名: R-PTP-S; PTPSIGMA; R-PTP-sigma应用: IHC反应种属: Human, Mouse, Rat
-
分类: 科研抗体货号: P10274别名: CYPH; CYP-20; USA-CYP; SnuCyp-20应用: IHC反应种属: Human, Mouse
-
分类: 科研抗体货号: P10253别名: PM227; AHNAKRS应用: IHC反应种属: Human

鄂公网安备42018502007531号
鄂公网安备42018502007531号

